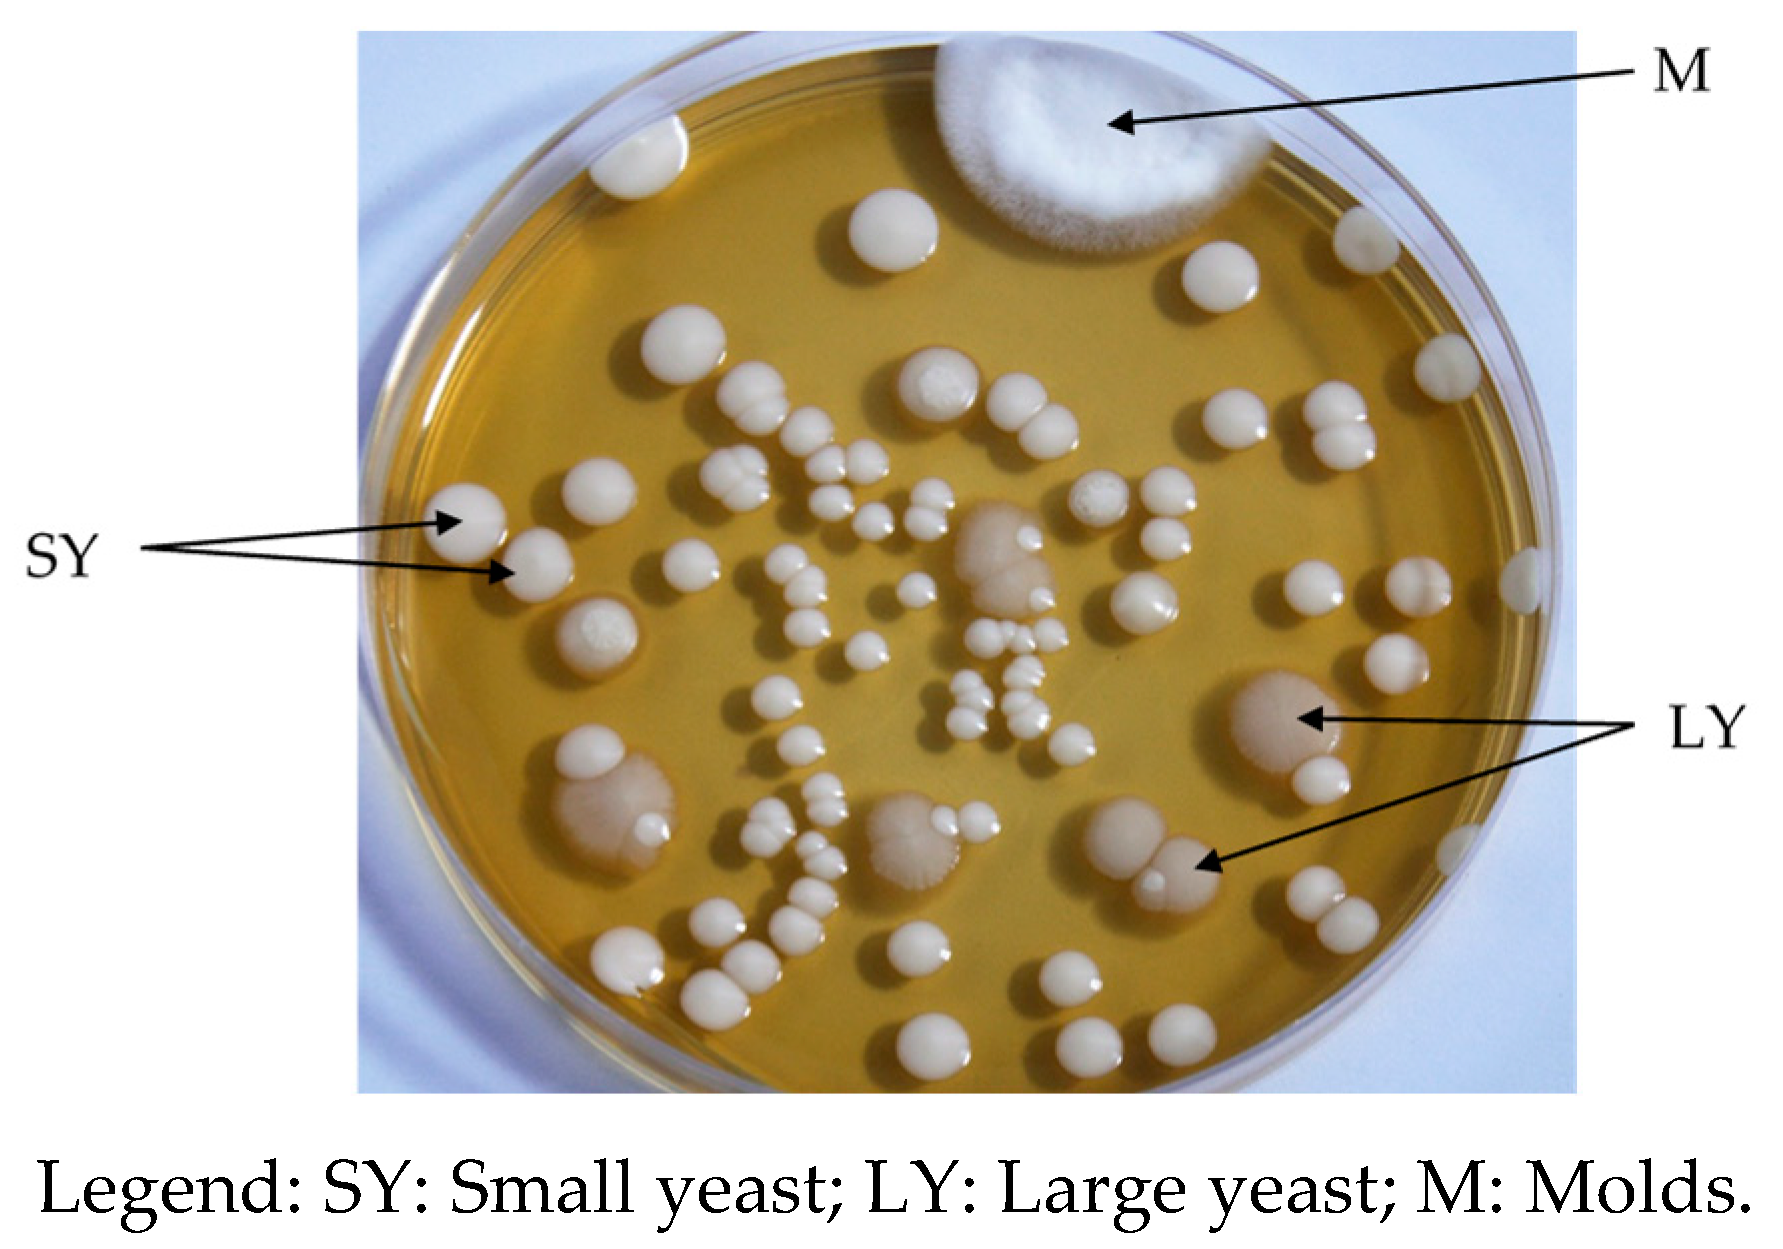

Preliminary Studies on the Variation in Microbial Succession, Physico-Chemical Characteristics and Antioxidant Capacity during a Spontaneous Fermentation of Mutchayan, a Traditional Fermented Baobab Derived Food †
Abstract
1. Introduction
2. Materials and Methods
2.1. Materials
2.2. Mutchayan Production and Sampling
2.3. Physico-Chemical Analyses
2.4. Nutritional Analyses
2.4.1. Preparation of Extracts
2.4.2. Assessment of Ascorbic Acid Content and Antioxidant Capacity
2.5. Microbiological Analyses
2.6. Statistical Analyses
3. Results
3.1. Physico-Chemical Characteristics of Mutchayan during a Spontaneous Fermentation
3.2. Microbial Changes during Mutchayan Fermentation
4. Discussion
5. Conclusions
Author Contributions
Funding
Institutional Review Board Statement
Informed Consent Statement
Data Availability Statement
Acknowledgments
Conflicts of Interest
References
- Ross, R.P.; Morgan, S.; Hill, C. Preservation and fermentation: Past, present and future. Int. J. Food Microbiol. 2002, 79, 3–16. [Google Scholar] [CrossRef] [PubMed]
- Liu, X.; Narbad, A. Lactic Acid Bacteria-Based Foods Fermentations. In Lactic Acid Bacteria in Foodborne Hazards Reduction; Springer, Ed.; Springer: Singapore, 2018; pp. 141–181. [Google Scholar]
- Katina, K.; Arendt, E.; Liukkonen, K.-H.; Autio, K.; Flander, L.; Poutanen, K. Potential of sourdough for healthier cereal products. Trends Food Sci. Technol. 2005, 16, 104–112. [Google Scholar] [CrossRef]
- Wacoo, A.P.; Mukisa, I.M.; Meeme, R.; Byakika, S.; Wendiro, D.; Sybesma, W.; Kort, R. Probiotic Enrichment and Reduction of Aflatoxins in a Traditional African Maize-Based Fermented Food. Nutrients 2019, 11, 265. [Google Scholar] [CrossRef] [PubMed]
- Hounhouigan, D.J.; Nout, M.J.R.; Nago, C.M.; Houben, J.H. Composition and microbiological and physical attributes of mawè, a fermented maize dough from Benin. Int. J. Food Sci. Technol. 1993, 28, 513–517. [Google Scholar] [CrossRef]
- Nago, M.C.; Hounhouigan, J.D.; Zanou, E.; Akissoe, N.; Mestres, C. Characterization of the Beninese traditional ogi, a fermented maize slurry: Physicochemical and microbiological aspects. Int. J. Food Sci. Technol. 1998, 33, 307–315. [Google Scholar] [CrossRef]
- Michodjehoun-Mestres, L.; Hounhouigan, D.J.; Dossou, J.; Mestres, C. Physical, chemical and microbiological changes during natural fermentation of" gowé", a sprouted or non sprouted sorghum beverage form West-Africa. Afr. J. Biotechnol. 2005, 4, 487–496. [Google Scholar]
- Chadare, F.J.; Gayet, D.P.; Azokpota, P.; Nout, M.J.R.; Linnemann, A.R.; Hounhouigan, J.D.; Van Boekel, M.A.J.S. Three Traditional Fermented Baobab Foods from Benin, Mutchayan, Dikouanyouri, andTayohounta: Preparation, Properties, and Consumption. Ecol. Food Nutr. 2010, 49, 279–297. [Google Scholar] [CrossRef]
- El Sheikha, A.F.; Montet, D. African Fermented Foods: Historical Roots and Real Benefits. In Microorganisms and Fermentation of Traditional Foods; Ray, R.C., Montet, D., Eds.; CRC Press: Boca Raton, FL, USA, 2014; pp. 188–222. [Google Scholar]
- Adebo, O.A.; Njobeh, P.B.; Kayitesi, E. Fermentation by Lactobacillus fermentum strains (singly and in combination) enhances the properties of ting from two whole grain sorghum types. J. Cereal Sci. 2018, 82, 49–56. [Google Scholar] [CrossRef]
- Montet, D.; Ray, R.C.; Zakhia-Rozis, N. Lactic Acid Fermentation of Vegetables and Fruits. In Microorganisms and Fermentation of Traditional Foods; Ray, R.C., Montet, D., Eds.; CRC Press: Boca Raton, FL, USA, 2014; p. 392. [Google Scholar]
- Chadare, F.J.; Linnemann, A.R.; Hounhouigan, J.D.; Nout, M.J.R.; van Boekel, M.A.J.S. Baobab Food Products: A review on their Composition and Nutritonal Value. Crit. Rev. Food Sci. Nutr. 2009, 49, 254–274. [Google Scholar] [CrossRef]
- Braca, A.; Sinisgalli, C.; De Leo, M.; Muscatello, B.; Cioni, P.L.; Milella, L.; Ostuni, A.; Giani, S.; Sanogo, R. Phytochemical Profile, Antioxidant and Antidiabetic Activities of Adansonia digitata L. (Baobab) from Mali, as a Source of Health-Promoting Compounds. Molecules 2018, 23, 3104. [Google Scholar] [CrossRef]
- RRusso, M.; Ronci, M.B.; Vilmercati, A.; Gionfriddo, M.; Fanali, C.; Dugo, L.; Locato, V.; Mondello, L.; De Gara, L. African baobab (Adansonia digitata) fruit as promising source of procyanidins. Eur. Food Res. Technol. 2019, 246, 297–306. [Google Scholar] [CrossRef]
- Ismail, B.B.; Pu, Y.; Guo, M.; Ma, X.; Liu, D. LC-MS/QTOF identification of phytochemicals and the effects of solvents on phenolic constituents and antioxidant activity of baobab (Adansonia digitata) fruit pulp. Food Chem. 2019, 277, 279–288. [Google Scholar] [CrossRef] [PubMed]
- Sokeng, A.J.T.; Sobolev, A.P.; Di Lorenzo, A.; Xiao, J.; Mannina, L.; Capitani, D.; Daglia, M. Metabolite characterization of powdered fruits and leaves from Adansonia digitata L. (baobab): A multi-methodological approach. Food Chem. 2018, 272, 93–108. [Google Scholar] [CrossRef] [PubMed]
- ISO. Fruits and Vegetables Products—Determination of Ph; ISO: Geneva, Switzerland, 1991. [Google Scholar]
- ISO. Fruits and Vegetables Products—Determination of Titratable Acidity; ISO: Geneva, Switzerland, 1998. [Google Scholar]
- AOAC. Official Methods of Analysis of the Association of Official Analytical Chemists, 13th ed.; Association of Official Analytical Chemists: Washington DC, USA, 1980; p. 1040. [Google Scholar]
- ISO. Fruit and Vegetable Products—Determination of Soluble Solids—Refractometric Method; ISO: Geneva, Switzerland, 2003. [Google Scholar]
- Tembo, D.T.; Holmes, M.J.; Marshall, L.J. Effect of thermal treatment and storage on bioactive compounds, organic acids and antioxidant activity of baobab fruit (Adansonia digitata) pulp from Malawi. J. Food Compos. Anal. 2017, 58, 40–51. [Google Scholar] [CrossRef]
- Thaipong, K.; Boonprakob, U.; Crosby, K.; Cisneros-Zevallos, L.; Hawkins Byrne, D. Comparison of ABTS, DPPH, FRAP, and ORAC assays for estimating antioxidant activity from guava fruit extracts. J. Food Compos. Anal. 2006, 19, 669–675. [Google Scholar] [CrossRef]
- ISO. Fruits, Vegetables and Derived Products—Determination of Acid Ascorbic Content—Part 2: Routine Methods; ISO: Geneva, Switzerland, 1984. [Google Scholar]
- Brand-Williams, W.; Cuvelier, M.E.; Berset, C. Use of a free radical method to evaluate antioxidant activity. LWT Food Sci. Technol. 1995, 28, 25–30. [Google Scholar] [CrossRef]
- ISO. Microbiology of Food and Animal Feeding of Stuffs—General Requirements and Guidance for Microbiological Examinations; ISO: Geneva, Switzerland, 2007. [Google Scholar]
- ISO. Microbiology of the Food Chain—Horizontal Method for the Enumeration of Microorganisms, in Part 1: Colony Count at 30°C by the Pour Plate Technique; ISO: Geneva, Switzerland, 2013. [Google Scholar]
- ISO. Microbiology of Food and Animal Feeding Stuffs—Horizontal Method for the Enumeration of Mesophilic Lactic Acid Bacteria—Colony Count Technique at 30 °C; ISO: Geneva, Switzerland, 1998. [Google Scholar]
- ISO. Microbiology of Food and Animal Feeding Stuffs—Horizontal Method for the Enumeration of Yeasts and Moulds—, in Part 2: Colony Count Technique in Products with Water Activity Less than or Equal to 0,95; ISO: Geneva, Switzerland, 2008. [Google Scholar]
- ISO. Microbiology of Food and Animal Feeding Stuffs—Horizontal Methods for the Detection and Enumeration of Enterobacteriaceae in Part 2: Colony Count Method; ISO: Geneva, Switzerland, 2004. [Google Scholar]
- Zeileis, A.; Kleiber, C.; Jackman, S. Regression Models for Count Data in R. J. Stat. Softw. 2008, 27, 25. [Google Scholar] [CrossRef]
- Muoka, A.K.; Ngesa, O.O.; Waititu, A.G. Statistical Models for Count Data. Sci. J. Appl. Math. Stat. 2016, 4, 256. [Google Scholar] [CrossRef][Green Version]
- Bangar, S.P.; Suri, S.; Trif, M.; Ozogul, F. Organic acids production from lactic acid bacteria: A preservation approach. Food Biosci. 2022, 46, 101615. [Google Scholar] [CrossRef]
- Hounhouigan, D.; Nout, M.; Nago, C.; Houben, J.; Rombouts, F. Changes in the Physico-Chemical Properties of Maize During Natural Fermentation of Mawè. J. Cereal Sci. 1993, 17, 291–300. [Google Scholar] [CrossRef]
- Racchi, I.; Scaramuzza, N.; Hidalgo, A.; Berni, E. Combined effect of water activity and pH on the growth of food-related ascospore-forming molds. Ann. Microbiol. 2020, 70, 69. [Google Scholar] [CrossRef]
- Santos, J.L.P.D.; Samapundo, S.; Biyikli, A.; van Impe, J.; Akkermans, S.; Höfte, M.; Abatih, E.N.; Sant'Ana, A.S.; Devlieghere, F. Occurrence, distribution and contamination levels of heat-resistant moulds throughout the processing of pasteurized high-acid fruit products. Int. J. Food Microbiol. 2018, 281, 72–81. [Google Scholar] [CrossRef] [PubMed]
- Quattrini, M.; Bernardi, C.; Stuknytė, M.; Masotti, F.; Passera, A.; Ricci, G.; Vallone, L.; De Noni, I.; Brasca, M.; Fortina, M.G. Functional characterization of Lactobacillus plantarum ITEM 17215: A potential biocontrol agent of fungi with plant growth promoting traits, able to enhance the nutritional value of cereal products. Food Res. Int. 2018, 106, 936–944. [Google Scholar] [CrossRef] [PubMed]
- Rizzello, C.G.; Lorusso, A.; Montemurro, M.; Gobbetti, M. Use of sourdough made with quinoa (Chenopodium quinoa) flour and autochthonous selected lactic acid bacteria for enhancing the nutritional, textural and sensory features of white bread. Food Microbiol. 2016, 56, 1–13. [Google Scholar] [CrossRef] [PubMed]
- Delali, K.I.; Chen, O.; Wang, W.; Yi, L.; Deng, L.; Zeng, K. Evaluation of yeast isolates from kimchi with antagonistic activity against green mold in citrus and elucidating the action mechanisms of three yeast: P. kudriavzevii, K. marxianus, and Y. lipolytica. Postharvest Biol. Technol. 2021, 176, 111495. [Google Scholar] [CrossRef]
- Gotcheva, V.; Pandiella, S.S.; Angelov, A.; Roshkova, Z.; Webb, C. MMonitoring the fermentation of the traditional Bulgarian beverage boza. Int. J. Food Sci. Technol. 2001, 36, 129–134. [Google Scholar] [CrossRef]
- Adinsi, L.; Mestres, C.; Akissoé, N.; Vieira-Dalodé, G.; Anihouvi, V.; Durand, N.; Hounhouigan, D.J. Comprehensive quality and potential hazards of gowe, a malted and fermented cereal beverage from West Africa. A diagnostic for a future re-engineering. Food Control 2017, 82, 18–25. [Google Scholar] [CrossRef]
- Miguel, M.G.d.P.; Santos, M.R.R.M.; Duarte, W.F.; de Almeida, E.G.; Schwan, R.F. Physico-chemical and microbiological characterization of corn and rice ‘calugi’ produced by Brazilian Amerindian people. Food Res. Int. 2012, 49, 524–532. [Google Scholar] [CrossRef]
- Assohoun-Djeni, N.; Messaoudi, S.; Lhomme, E.; Koussemon-Camara, M.; Ouassa, T.; Chobert, J.-M.; Onno, B.; Dousset, X. Biodiversity, dynamics and antimicrobial activity of lactic acid bacteria involved in the fermentation of maize flour for doklu production in Côte d'Ivoire. Food Control 2016, 62, 397–404. [Google Scholar] [CrossRef]
- Onda, T.; Yanagida, F.; Tsuji, M.; Shinohara, T.; Yokotsuka, K. Time series analysis of aerobic bacterial flora during Miso fermentation. Lett. Appl. Microbiol. 2003, 37, 162–168. [Google Scholar] [CrossRef]
- Catzeddu, P. Chapter 14—Sourdough Breads. In Flour and Breads and Their Fortification in Health and Disease Prevention (Second Edition); Preedy, V.R., Watson, R.R., Eds.; Academic Press: Cambridge, MA, USA, 2019; pp. 177–188. [Google Scholar]

| Products Analyzed | pH | °Brix | TTA (LA g/100 g dw) | DM (g/100 g) | Ascorbic Acid (mg/100 g dw) | Antioxidant Capacity (VCEAC mg/100 g dw) |
|---|---|---|---|---|---|---|
| Mutchayan at 0 h | 3.4 ± 0.0 a | 7.3 ± 0.3 a | 5.8 ± 0.1 e.f | 18.7 ± 0.1 a | 91.7 ± 1.1 a | 693.5 ± 49.0 a.b |
| Mutchayan at 6 h | 3.4 ± 0.0 a | 7.6 ± 0.1 a | 5.7 ± 0.1 f | 18.7 ± 0.3 a | 84.7 ± 3.8 a.b | 699.2 ± 51.7 a.b |
| Mutchayan at 12 h | 3.3 ± 0.0 a | 7.5 ± 0.4 a | 6.0 ± 0.0 d.e | 18.6 ± 0.2 a | 79.1 ± 5.0 a.b | 677.7 ± 0.7 a.b |
| Mutchayan at 24 h | 3.3 ± 0.0 a | 7.4 ± 0.2 a | 6.1 ± 0.0 d.e | 18.3 ± 0.0 b | 69.8 ± 4.0 b | 657.1 ± 1.2 b |
| Mutchayan at 36 h | 3.4 ± 0.0 a | 6.8 ± 0.5 a | 6.3 ± 0.0 c.d | 18.1 ± 0.0 b | 78.8 ± 8.1 a.b | 713.8 ± 43.1 a.b |
| Mutchayan at 48 h | 3.4 ± 0.0 a | 6.0 ± 0.4 a.b | 6.5 ± 0.1 a.b.c | 17.5 ± 0.0 c | 80.8 ± 1.1 a.b | 802.9 ± 48.9 a |
| Mutchayan at 72 h | 3.3 ± 0.0 a | 6.2 ± 0.9 a.b | 6.8 ± 0.1 a | 16.9 ± 0.0 d | 76.6 ± 0.9 a.b | 766.1 ± 0.0 a.b |
| Mutchayan at 96 h | 3.3 ± 0.0 a | 5.0 ± 0.0 b | 6.6 ± 0.1 a.b | 16.9 ± 0.1 d | 79.3 ± 0.0 a.b | 751.5 ± 17.9 a.b |
| Mutchayan at 120 h | 3.4 ± 0.1 a | 5.1 ± 0.4 b | 6.3 ± 0.1 b.c.d | 16.7 ± 0.1 d | 82.6 ± 3.9 a.b | 798.2 ± 23.2 a |
| Sorghum flour | 6.1 ± 0.0 | 8.2 ± 0.3 | 0.6 ± 0.0 | 91.3 ± 0.1 | 0.0 ± 0.0 | NA |
| Baobab pulp | 3.1 ± 0.0 | 73.4 ± 1.7 | 14.4 ± 0.1 | 87.3 ± 0.5 | 299.3 ± 4.4 | 3004.6 ± 1.6 |
| Mutchayan at | TVC | MC | EC |
|---|---|---|---|
| 0 h | 3.5 × 103 ± 2.3 × 103 c | 500 ± 0 | <10 |
| 6 h | 4.2 × 103 ± 2.5 × 103 c | 1000 ± 0 | <10 |
| 12 h | 6.6 × 103 ± 0.8 × 103 c | 500 ± 0 | 50 ± 14 b |
| 24 h | 8.4 × 106 ± 9.9 × 106 b | <4 × 106 | <10 |
| 36 h | 6.9 × 107 ± 5.6 × 107 a | 8 × 106 ± 0.0 | 115 ± 7 a |
| 48 h | 4.7 × 107 ± 0.6 × 107 a | <4 × 105 | <10 |
| 72 h | 10.5 × 107 ± 3.7 × 107 a | <4 × 106 | NA |
| 96 h | 14.6 × 107 ± 5.8 × 107 a | 4 × 106 ± 0.0 | NA |
| 120 h | 14.2 × 107 ± 2.3 × 107 a | <4 × 106 | NA |
| Mutchayan at | YC | SYC | LYC | pLABC |
|---|---|---|---|---|
| Mutchayan at 0 h | <100 | <100 | <100 | <10 |
| Mutchayan at 6 h | <100 | <100 | <100 | <10 |
| Mutchayan at 12 h | 6.5 × 102 ± 7.8 × 102 d | 6.5 × 102 ± 7.8 × 102 d | <100 | 2.4 × 102 ± 3.0 × 102 d |
| Mutchayan at 24 h | 10.2 × 106 ± 7.7 × 105 c | 9.6 × 106 ± 6.4 × 103 c | 1.2 × 106 ± 0.0 c | 4.6 × 106 ± 5.3 × 106 c |
| Mutchayan at 36 h | 2.3 × 107 ± 0.7 × 107 b | 2.1 × 107 ± 0.5 × 107 b,c | 2.5 × 106 ± 0.0 b,c | 2.6 × 107 ± 1.2 × 107 b |
| Mutchayan at 48 h | 7.9 × 107 ± 2.2 × 107 a | 7.0 × 107 ± 0.9 × 107 a,b | 1.9 × 107 ± 0.0 a | 5.7 × 107 ± 0.3 × 107 a,b |
| Mutchayan at 72 h | 8.9 × 107 ± 5.1 × 107 a | 8.6 × 107 ± 5.5 × 107 a | 3.7 × 106 ± 3.8 × 106 b,c | 6.4 × 107 ± 4.1 × 107 a,b |
| Mutchayan at 96 h | 8.1 × 107 ± 0.8 × 107 a | 7.5 × 107 ± 0.1 × 107 a,b | 1.4 × 107 ± 0.0 a,b | 11.2 × 107 ± 0.8 × 107 a |
| Mutchayan at 120 h | 10.1 × 107 ± 1.3 × 107 a | 9.2 × 107 ± 2.5 × 107 a | 4.1 × 107 ± 0.0 a | 13.0 × 107 ± 0.8 × 107 a |
Disclaimer/Publisher’s Note: The statements, opinions and data contained in all publications are solely those of the individual author(s) and contributor(s) and not of MDPI and/or the editor(s). MDPI and/or the editor(s) disclaim responsibility for any injury to people or property resulting from any ideas, methods, instructions or products referred to in the content. |
© 2022 by the authors. Licensee MDPI, Basel, Switzerland. This article is an open access article distributed under the terms and conditions of the Creative Commons Attribution (CC BY) license (https://creativecommons.org/licenses/by/4.0/).
Share and Cite
Gbaguidi, A.M.; Chadare, F.J.; Padonou, S.W.; Assou, C.O.; Hounhouigan, D.J. Preliminary Studies on the Variation in Microbial Succession, Physico-Chemical Characteristics and Antioxidant Capacity during a Spontaneous Fermentation of Mutchayan, a Traditional Fermented Baobab Derived Food. Biol. Life Sci. Forum 2021, 6, 124. https://doi.org/10.3390/Foods2021-10989
Gbaguidi AM, Chadare FJ, Padonou SW, Assou CO, Hounhouigan DJ. Preliminary Studies on the Variation in Microbial Succession, Physico-Chemical Characteristics and Antioxidant Capacity during a Spontaneous Fermentation of Mutchayan, a Traditional Fermented Baobab Derived Food. Biology and Life Sciences Forum. 2021; 6(1):124. https://doi.org/10.3390/Foods2021-10989
Chicago/Turabian StyleGbaguidi, Ahotondji Mechak, Flora Josiane Chadare, Sègla Wilfrid Padonou, Comlanvi Oscar Assou, and Djidjoho Joseph Hounhouigan. 2021. "Preliminary Studies on the Variation in Microbial Succession, Physico-Chemical Characteristics and Antioxidant Capacity during a Spontaneous Fermentation of Mutchayan, a Traditional Fermented Baobab Derived Food" Biology and Life Sciences Forum 6, no. 1: 124. https://doi.org/10.3390/Foods2021-10989
APA StyleGbaguidi, A. M., Chadare, F. J., Padonou, S. W., Assou, C. O., & Hounhouigan, D. J. (2021). Preliminary Studies on the Variation in Microbial Succession, Physico-Chemical Characteristics and Antioxidant Capacity during a Spontaneous Fermentation of Mutchayan, a Traditional Fermented Baobab Derived Food. Biology and Life Sciences Forum, 6(1), 124. https://doi.org/10.3390/Foods2021-10989






